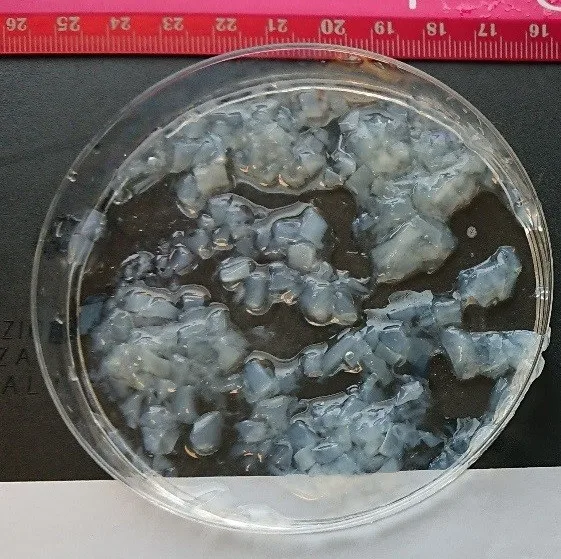

NATA DE COCO для производства напитков/кокосовых продуктов/Vivian Ha + 84 33 88
- Категории: Other Food & Beverage >>>
- Поставщик: VIET,D.E.L.T.A,INDUSTRIAL,CO.,LTD
Поделиться:
Описание и отзывы
Характеристики
VIET DELTA CO. LTD
Viet Delta In. Co., Ltd was found in 2003, has built a strong relationship with the local farmers, fisherman, manufacturing Seafood and argicultural products for exporting in Vietnam.
Viet Delta's products have been exported all over the world: Taiwan, Japan, Korea, Singapore, Saudi Arabia, Italia, Russia, Britain, France, Germany, Turkey, India, Egypt, South Africa, Algeria, Paraguay, Uruguay, United States, Australia, Malaysia, ...
Viet Delta is a member of the Vietnam Chamber of Commerce and Industry (VCCI), a member of Vietnam Food Association (VFA), a member of the Association of Fruit Vietnam (Vinafruit), Ben Tre coconut Association.
ITEM | NATA DE COCO |
BRIX | Light syrup (10-12; 14-16); Heavy syrup (18-20) as buyer's request. |
SIZE | sheet, 3mm, 5mm, 8mm, 10mm, 15mm |
FLAVOUR | sweet or no sugar |
INGREDIENT | 80% jelly, 20% syrup or 50/50; 40/60 ( as buyer's requests) |
pH | 3-3.8 |

PACKAGING
In bag of 500gr, 1kg, 2kgs, 5kgs and 10kgs and jar
DELIVERY: EXW, FOB, CFR, CIF
PAYMENT: T/T 30% advance; L/C
1. Sample is free?
In according to our company policy, sample is free but transport cost will belong to your side.
2. What documents you will be provided?
Full of Bill of lading, Commercial Invoice, Packing list and Origin certificate, or as your special requirements.
If you need further information, just please contact with me,
Looking forward to your feedback.























